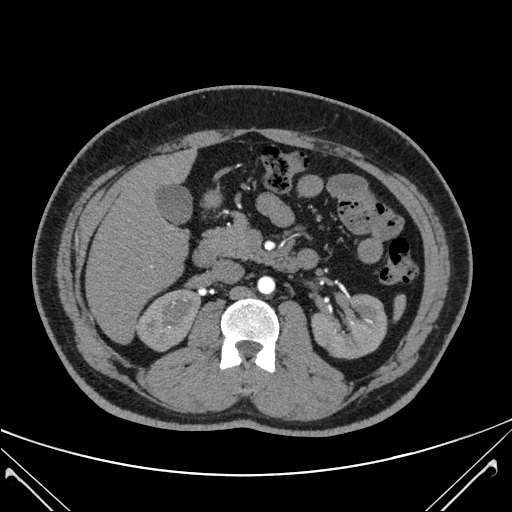

At MediPaws, we offer advanced diagnostic imaging to help uncover the root cause of complex health issues. Our imaging suite includes a high-field 1.5 Tesla MRI scanner and the region’s only SPECT-CT unit commissioned specifically for veterinary use. Our advanced imaging tools help us diagnose and treat complex conditions, such as Pyrexia of Unknown Origin (PUO) or rare neurological cases.
Diagnostic Imaging refers to the use of various techniques that allow veterinarians to visualise the internal structures of your pet’s body for the purpose of diagnosing, treating, and monitoring a wide range of health conditions. Our imaging suite include advanced tools, such as SPECT-CT and MRI, alongside essential modalities such as X-rays and ultrasound.
Our diagnostic imaging process is tailored to your pet’s condition and comfort. Your primary veterinarian and our imaging specialists will collaborate to choose the most suitable method. Depending on the technique used, your pet may be awake (for ultrasounds and most X-rays) or may require sedation or general anaesthesia (particularly for CT or MRI) to ensure stillness and accuracy during the procedure. We’ll always explain what to expect and guide you through the process every step of the way.
SPECT-CT combines two types of imaging to visualise both organ function and anatomical structure. MediPaws has the only veterinary-commissioned SPECT-CT scanner in the Sydney region. Our imaging team uses it to diagnose and treat complex cases, such as unexplained fevers (PUO), immune-related conditions, or lameness.

CT scans produce detailed 3D images of your pet’s internal structures, helping us assess bones, joints, lungs, and organs with high precision. It’s especially useful for trauma cases, cancer investigations, and planning complex surgeries.
MRI provides high-resolution images of soft tissues, making it invaluable for diagnosing brain and spinal cord conditions, joint injuries, and soft tissue tumours in pets – all without using radiation.

X-rays are a fast and effective way to examine your pet’s bones, chest, and abdomen. They’re commonly used to detect fractures, arthritis, tumours, and ingested foreign objects.

Fluoroscopy is a medical imaging technique that uses continuous x-rays to create moving images of your pet’s internal structures. It is used to diagnose a wide variety of conditions in veterinary patients, including swallowing issues, urinary tract disease, or respiratory issues.

Ultrasound uses sound waves to create real-time images of your pet’s internal organs. It’s often used to assess heart conditions, abdominal issues, and pregnancy, without the need for sedation or radiation.

Our Diagnostic Imaging Specialists are veterinarians with advanced training in interpreting imaging studies and providing accurate diagnoses. They work closely with your pet’s healthcare team to ensure that imaging findings are integrated into a tailored treatment plan.
Most diagnostic imaging procedures are non-invasive and generally well-tolerated by pets. We take every precaution to minimise stress and discomfort during the process. If sedation or anaesthesia is required, we prioritise your pet’s safety and wellbeing with constant monitoring throughout the procedure. As with any procedure, there are always risks involved, and your veterinarian will go through these with you in detail during your consultation.
Preparing your pet may involve fasting before certain procedures or following other specific instructions provided by our team. We’ll ensure that you have all the information you need for a smooth and comfortable experience. Don’t hesitate to reach out with any questions or concerns.

Finding urine outside the litter tray can be frustrating and worrying. But...
Brachycephalic breeds are predisposed to fluid accumulation in the Tympanic Bulla (TB)....
Intertriginous dermatitis (aka intertrigo) refers to inflammation and/or infection of any skin...